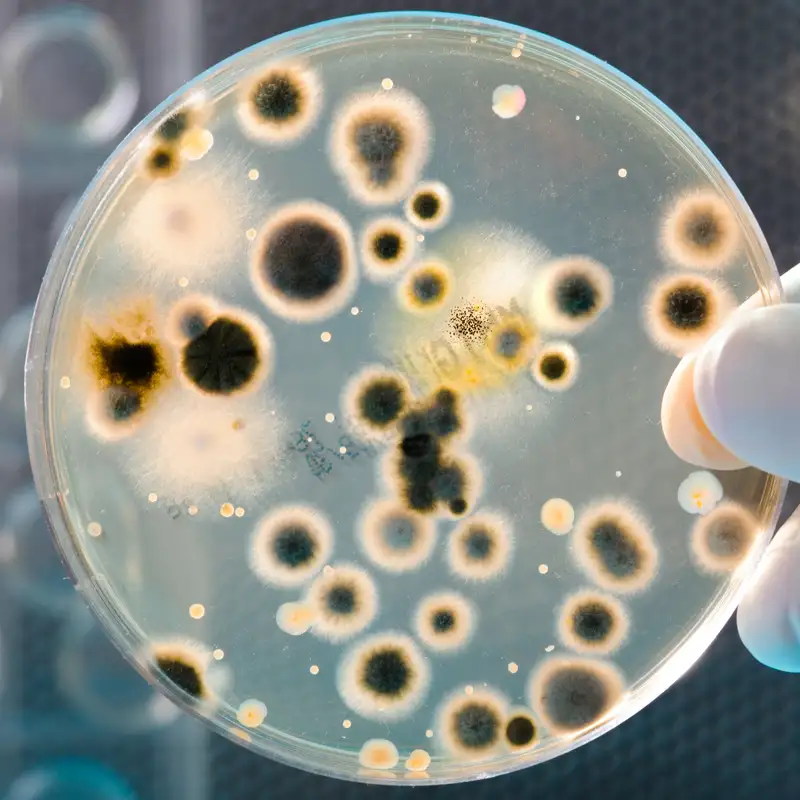

All Episodes
Displaying 61 - 80 of 123 in total
Growing Blueberries with Kathleen Demchak
What is the secret of growing blueberries successfully? In this episode of The Urban Forestry Radio Show and Podcast we speak to Kathleen Demchak, Senior Extension Ass...

Creating a "Tree of 40 Fruit" with Sam Van Aken
Sam Van Aken is an award winning artist and an associate professor in the Art Department of Syracuse University who uses grafting techniques to create his "Tree of 40 ...

When To Fertilize Fruit Trees with Robert Crassweller
When is the best time to fertilize fruit trees? In this episode Tree Fruit Production Extension Specialist Robert Crassweller, Ph.D. from Penn State College of Agricul...

Native Apple Trees with Paul Kron
Most apple trees that we grow in our gardens and orchards are not native to North America. DNA tells us that these trees originate in the mountains of Kazakhstan in Ce...

Apple Tasting Party with Yael Hickok and Dr. Amy Bowen
Yael Hickok is a volunteer who cares for Boyer's Orchard in Alaska. Each year she has an apple tasting party or gathering in which she and other volunteers are able to...

How to Prune Old Fruit Trees with Bob Lever
Old fruit trees may be hollow but they can still produce fantastic fruit and they provide invaluable habitat to wildlife, sometimes for very unique and specific specie...

Growing Fruit Trees in Extreme Climates with Greg Peterson
Growing fruit trees can be very difficult in extreme climates and no one would understand that better than Greg Peterson of UrbanFarm.org, who grows his fruit trees in...

Community Orchards in the UK and Beyond with Lewis McNeill
In this episode of The Urban Forestry Radio Show and Podcast, host Susan Poizner interviews Lewis McNeill of The Orchard Project about how they help nurture and suppor...

Bee Garden Design and Fruit Trees with Lorraine Johnson
Lorraine Johnson, co-author of the free eBook: "A Flower Patch for The Rusty-Patched Bumble Bee" explains how to use native plants to create a pollinator or bee garden...

Vertical Mulching and Worms in Soil with Glynn Percival
In this episode of The Urban Forestry Radio Show and Podcast we speak to Dr. Glynn Percival, Manager of Bartlett's Tree Research and Diagnostic Laboratory at the Unive...

Biochar and Fruit Trees with Mark and Laurie Mann
In recent years, there has been a lot of talk about how biochar can help boost the carbon levels in your soil. But what is biochar and how is it made? How is biochar d...

Cover Crops and Fruit Trees with Christina Curell
What are the benefits and the disadvantages of planting cover crops around fruit trees? Can cover crops on an orchard floor help prevent fruit trees from climate chang...

Fruit Tree Traps with Kristy Grigg-McGuffin
IPM specialist Kristy Grigg-McGuffin of the Ontario Ministry of Food and Rural Affairs talks about fruit tree traps - some monitor fruit tree pests while others help t...

Pawpaw Fruit Facts with Paul DeCampo and Isaac Crosby
Forget mangos and bananas. If you're interested in an exciting taste adventure in tropical fruit, check out the Native American pawpaw fruit. Now pawpaw fruit may be j...

Developing a Fruit Tree Spray Schedule with Mike Biltonen
If you’re growing your fruit trees organically, it’s important to protect them from pests and diseases and having a fruit tree spray schedule can make that much easier...

Growing Jesuit Pear Trees with Paul Spence
Jesuit pear trees also known as Mission pears. French Jesuit missionaries brought these productive trees to North America in the 1700s. Learn more about this heirloom ...

Luther Burbank's Garden of Invention with Rachel Spaeth
In this episode we explore the story of plant breeder Luther Burbank and we'll see how his discoveries still live on in our edible gardens today. Our guest is Rachel S...

What are Biofertilizers? with Simon Neufeld
In this episode, certified crop advisor Simon Neufeld talks about soil biology. Why is it important to have a lot of good organisms in your soil? What services do they...
Growing Perennial Vegetables with Ben Caesar
Ben Caesar of Fiddlehead Nursery in Ontario shares his top perennial vegetables to grow and create a fantastic dinner menu featuring many of his favourite edible peren...

Fruit Trees and Spotted Wing Drosophila with Nikki Rothwell
Nikki Rothwell of Michigan State University's Northwest Michigan Horticulture Research Centre talks about spotted wing drosophila (SWD). Unlike other fruit flies that ...

